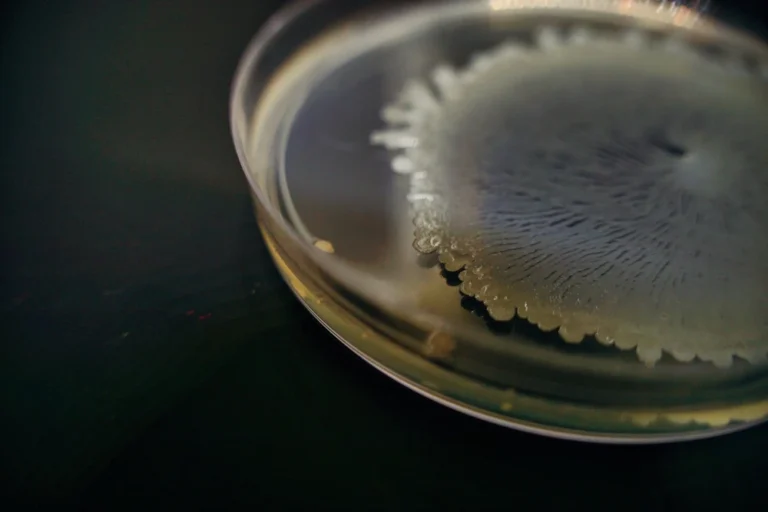
Bacillus pumilus

Bacillus pumilus para controle de doenças: como funciona?
Bacillus pumilus é um agente biológico que controla doenças ao fortalecer a planta e reduzir a pressão dos patógenos, sendo um aliado eficiente no manejo integrado....
BUSCAR
×
Bacillus pumilus é um agente biológico que controla doenças ao fortalecer a planta e reduzir a pressão dos patógenos, sendo um aliado eficiente no manejo integrado....

Com potencial para produzir, em média, 150 mil sementes por planta, o capim-colchão é uma planta daninha amplamente disseminada por todo o Brasil

Saiba como o Brasil tem se consolidado no mercado dos bioinsumos e como o bioinseticida pode ser um aliado no controle de pragas, como cigarrinha-do-milho, percevejos...

O nematoide-das-galhas possui mais de 2000 espécies hospedeiras e afeta o sistema radicular de uma ampla gama de culturas agrícolas

Presente em praticamente todo o Brasil, a tiririca é uma planta daninha que continua se mostrando um grande desafio para produtores, visto a sua agressividade e...

A grama-seda, comumente usada como forrageira, também pode se tornar uma planta daninha de difícil controle. Conheça a sua biologia, os danos que causa e as...

Confira o panorama do milho safrinha 2025: avanço do plantio, projeções de área, produção, desafios climáticos e fitossanitários

Lagartas do feijão causam perdas significativas; identificação e estratégias integradas são essenciais para controle eficaz. Conheça as soluções. A cultura do feijão é fundamental para a...

Pragas no feijão impactam a produção; identificar corretamente e aplicar controle eficaz garante lavouras mais produtivas. Aprofunde seus conhecimentos. O feijão (Phaseolus vulgaris) é uma das...

Plantas daninhas no feijão representam desafios que exigem estratégias de controle eficazes para manter a produção e a qualidade do grão; o manejo integrado é a...